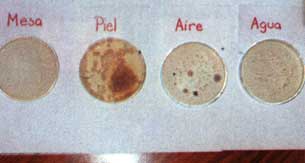

This chapter will examine all of the aspects that need to be considered in a successful food processing practice. It will analyze in general terms the sanitary management of a home processing system, which is very sensitive and often is characterized by serious failures deriving from the lack o: financial resources.
Quality and health standards and regulations must be strictly applied, or the product will be exposed to contamination by bacteria, mould and yeasts, thus jeopardizing the expected development of an agroindustrial enterprise.
Such measures must be adopted as early as in the production phase, and must continue in the post-harvest, transportation, storage, preparation and processing phases.
In line with these principles, the following sanitary standards must be fulfilled and applied by workers on the production premises:
- Workers must wash their hands and clean their nails carefully before engaging in any process. They must keep their nails short, and if possible, use rubber gloves.
- To enter the working area, workers must wear a clean smock, a hair net to protect the food from possible contamination by hair, and a mask to avoid microbial contamination.
- The working utensils and equipment must be cleaned appropriately to remove any waste or residual organic material.
- The containers (glass jars and bottles) must be washed with hot water before being filled with food.
- The waste generated by the production process must be removed from the production area on a daily basis.
- Clean and dry the outside of the containers with the product before labelling and storing.
- The storage site of the finished product must be clean and free from all possible contamination (it must have been previously fumigated). It must also be cool and dry.
- Once the working cycle has been completed, the production area must be left perfectly clean. It will therefore have to be pre-rinsed with water at a temperature of 40°C (to remove about 90% of the dirt), washed with detergent, and finally rinsed with water at a temperature of 38-46°C.
- Both the premises and the equipment will have to be disinfected on a fortnightly basis. Caustic soda will be applied first (2%), and then nitric acid (1.5%) at a temperature of 75 0 C after which they will be rinsed with water.
Whereas hygiene is a principle that applies to people, industrial health applies to the equipment, facilities and premises utilized in the production process. It is extremely important to adopt measures to ensure that the facilities meet the industrial health standards which guarantee an efficient implementation of the process.
These standards apply to small, medium and large enterprises and cottage industries alike, and should also be applied at the home level. They may be summarized as follows:
Picture 21. Note the smock, cap and mask to be worn on the job. (G. Paltrinieri)

Picture 22. Washing recyclable glass containers with sand. (G. Paltrinieri)

Picture 23. Storage of clean and sterilized glass containers (G. Paltrinieri)

Picture 24. Bottle and jar, extensively used in small-scale processing. (G. Paltrinieri)

Picture 25. Staff preparing dishes for the "seeding". (G. Paltrinieri)

Picture 26. Inoculated dishes with Petri results of inoculation after 4-6 days at 25-30°C. (Raquel Stagnaro)

Picture 27. Inoculated dishes with results after 4-6 days at 25-30°C (Raquel Stagnaro)
Picture 28. Test results of other dishes after 4-6 days at 25-30' C. (Raquel Stagnaro)

- The buildings must be adjusted so that they can be easily cleaned. There should be no blind spaces inaccessible to the cleaning and disinfection system.
- The equipment must be designed in such a way that no empty spaces are left to facilitate the accumulation of material that may decompose and cause severe contamination problems.
- All surfaces exposed to food must be properly cleaned and disinfected, with a frequency that will depend upon the type of raw material and process being used. Fruit and vegetable residues are generally easy to clean.
- A disinfection process can never be performed on a dirty surface. In order for the disinfection process to be successful, the surface must have been cleaned beforehand.
- The products used both in the cleaning and disinfection processes must be included in the list of products authorized by local health authorities. Special care must be taken to avoid polluting the environment by using products with an uncertain degradability.
- No disinfection process by itself will ever be able to replace the need for daily compliance with general sanitary requirements.
Picture 21 shows a worker wearing her working outfit, which, as may be observed, she keeps with great care. Picture 22 shows a group of women workers cleaning recycled glass containers by washing them with a detergent solution and using sand as an abrasive agent. Such containers are sterilized in boiling water before they are used, and are stored in clean bowls, as shown in picture 23.
To emphasize and help the staff of a food processing firm understand the importance of industrial sanitation and health, a simple test may be performed. All one needs is the cooperation of a centre equipped for the preparation of Petri dishes with a general-purpose microbiological culture medium like agar-starch-dextrose, and their subsequent incubation.
A certain number of Petri dishes are prepared and sterilized. If there is no university centre or a similar institution in the area, a local hospital may be asked to collaborate in the performance of this task. The dishes must be "seeded" with different elements that may constitute the source of possible microbiological contamination.
These may include the workers' hands, nails, hair or shoe soles (a smear is made in this case), the counters in the processing area (SMEAR), skin from the face of staff members (especially in the area near the mouth and nose), the air in the environment, the water utilized in the process and other elements that one might wish to analyze.
A smear is made by rubbing a sterilized cotton swab on the area to be analyzed and then on the agar surface. The cotton ball is normally placed on a wooden stick 10 cm long and 2-3 mm thick, so that it forms a small brush.
Picture 25 shows a working group with the sterilized dishes ready to be "seeded". After being inoculated, the dishes are properly marked, sealed, and are left to incubate at a temperature between 25 and 30°C. Qualitative findings will be observable after 4-6 days, and will be sufficient for a general analysis of the working environment.
Pictures 26 to 28 show the-dishes with different elements, some of which have exhibited remarkable micro-organism development, while others have not been characterized by any sort of growth process. It is interesting to observe that the particles collected from the workers' fingertips in the illustrated case did not elicit the development of microorganisms. The same may be said for the particles collected from the counters and the workers' hair, which is indicative of excellent sanitary and health conditions. On the other hand, it is important to observe that the water used in the tests and shown in the picture elicited minor but detectable microorganism growth. This is an important finding, as the water used was drinking water drawn from the general water supply system serving the institution involved, which was fed by a supposedly sterile deep well.
It is also interesting to note the contamination developed by skin particles, which in this case were collected from the forehead and the nose region of a production line woman worker.
The air from the environment was also found to be highly contaminated, probably by dust, unlike the sample containing particles from the cough of a worker with incipient influenza. Nail particles showed a small degree of micro-organism growth.
A similar test may be carried out periodically to monitor the general level of the working environment and to raise the awareness of the staff as to the need for personal as well as plant hygiene.